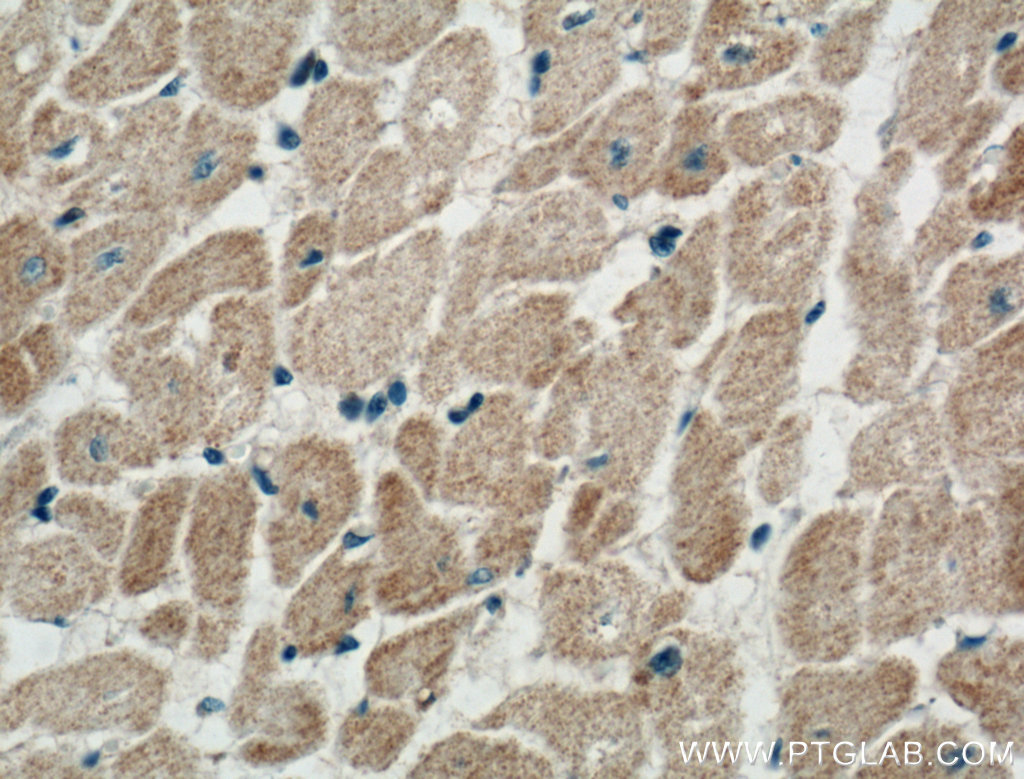

验证数据展示
经过测试的应用
| Positive WB detected in | mouse heart tissue, rat heart tissue |
| Positive IHC detected in | mouse heart tissue, human heart tissue Note: suggested antigen retrieval with TE buffer pH 9.0; (*) Alternatively, antigen retrieval may be performed with citrate buffer pH 6.0 |
| Positive IF/ICC detected in | C2C12 cells, HeLa cells |
推荐稀释比
| 应用 | 推荐稀释比 |
|---|---|
| Western Blot (WB) | WB : 1:2000-1:16000 |
| Immunohistochemistry (IHC) | IHC : 1:50-1:500 |
| Immunofluorescence (IF)/ICC | IF/ICC : 1:50-1:500 |
| It is recommended that this reagent should be titrated in each testing system to obtain optimal results. | |
| Sample-dependent, Check data in validation data gallery. | |
产品信息
27426-1-AP targets NPPA in WB, IHC, IF/ICC, ELISA applications and shows reactivity with human, mouse, rat samples.
| 经测试应用 | WB, IHC, IF/ICC, ELISA Application Description |
| 文献引用应用 | WB, IHC, ELISA |
| 经测试反应性 | human, mouse, rat |
| 文献引用反应性 | human, mouse, rat, goat |
| 免疫原 |
CatNo: Ag26692 Product name: Recombinant human NPPA protein Source: e coli.-derived, PGEX-4T Tag: GST Domain: 26-153 aa of BC005893 Sequence: NPMYNAVSNADLMDFKNLLDHLEEKMPLEDEVVPPQVLSEPNEEAGAALSPLPEVPPWTGEVSPAQRDGGALGRGPWDSSDRSALLKSKLRALLTAPRSLRRSSCFGGRMDRIGAQSGLGCNSFRYRR 种属同源性预测 |
| 宿主/亚型 | Rabbit / IgG |
| 抗体类别 | Polyclonal |
| 产品类型 | Antibody |
| 全称 | natriuretic peptide precursor A |
| 别名 | ANP, PND, ANF, ATFB6, Atrial natriuretic factor |
| 计算分子量 | 153 aa, 17 kDa |
| 观测分子量 | 19 kDa |
| GenBank蛋白编号 | BC005893 |
| 基因名称 | NPPA |
| Gene ID (NCBI) | 4878 |
| RRID | AB_2880868 |
| 偶联类型 | Unconjugated |
| 形式 | Liquid |
| 纯化方式 | Antigen affinity purification |
| UNIPROT ID | P01160 |
| 储存缓冲液 | PBS with 0.02% sodium azide and 50% glycerol, pH 7.3. |
| 储存条件 | Store at -20°C. Stable for one year after shipment. Aliquoting is unnecessary for -20oC storage. |
背景介绍
Natriuretic peptide precursor-A (NPPA) is an early and specific marker for functional myocardium of the embryonic heart. This protein is synthesized as a large precursor (containing a signal peptide), which is processed to release a peptide from the N-terminus with similarity to vasoactive peptide, cardiodilatin, and another peptide from the C-terminus with natriuretic-diuretic activity. NPPA is expressed primarily in the heart, where the expression level is higher in atria than ventricles. Low levels of ANP expression have been detected in other tissues, including the lung, aorta, brain, adrenal gland, kidney and uterus.
实验方案
| Product Specific Protocols | |
|---|---|
| IF protocol for NPPA antibody 27426-1-AP | Download protocol |
| IHC protocol for NPPA antibody 27426-1-AP | Download protocol |
| WB protocol for NPPA antibody 27426-1-AP | Download protocol |
| Standard Protocols | |
|---|---|
| Click here to view our Standard Protocols |
发表文章
| Species | Application | Title |
|---|---|---|
Clin Transl Med PINK1 modulates Prdx2 to reduce lipotoxicity-induced apoptosis and attenuate cardiac dysfunction in heart failure mice with a preserved ejection fraction | ||
Mol Ther Nucleic Acids Overexpression of cytosolic long noncoding RNA cytb protects against pressure-overload-induced heart failure via sponging microRNA-103-3p. | ||
Biochim Biophys Acta Mol Basis Dis Soluble epoxide hydrolase and TRPC3 channels jointly contribute to homocysteine-induced cardiac hypertrophy: Interrelation and regulation by C/EBPβ | ||
Pharmacol Res Cullin-associated and neddylation-dissociated 1 protein (CAND1) governs cardiac hypertrophy and heart failure partially through regulating calcineurin degradation. | ||
J Cell Mol Med The total xanthones extracted from Gentianella acuta alleviates HFpEF by activating the IRE1α/Xbp1s pathway |